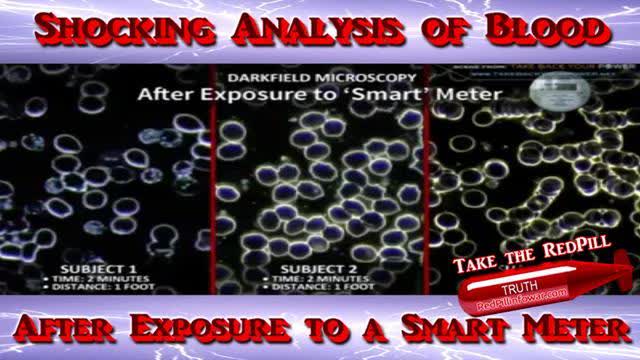
Shocking Analysis of Blood after Exposure to a Smart Meter

Search results "Exposure"
Relevant Videos
-
Watch Later
 00:01
00:01Shocking Analysis of Blood after Exposure to a Smart Meter
WhiteBrightLight311 views 1392 days ago -
Watch Later
 00:01
00:01Jim and Denier Bud, Auschwitz Ultimate Exposure, May 27, 2023
Holotruther455 views 1011 days ago -
Watch Later
 00:01
00:01DEVASTATING EXPOSURE! Israel Infuriated! Nations Rush to Defund. Is This the End of The U.N.
Sama_El114 views 765 days ago -
Watch Later
 00:01
00:01Kermit The Frog Indecent Exposure PBS Accused Of Grooming Children With Sexualized LGBTQ Content
MaverickArtist228 views 637 days ago -
Watch Later
 00:01
00:01UFO Exposure Welcome To The Knowledge Apocalypse Karen Ann Lucyk MacDonald Robert Bower Victor Hugo
MaverickArtist126 views 399 days ago -
Watch Later
 00:01
00:01(NTP) report March 2023 arly-life fluoride exposure is associated with lower IQ in children
lababouche56 views 379 days ago -
Watch Later
 01:06:27
01:06:27'Anti-Semitism' hysteria - a scam to silence free speech and exposure of Israel Apartheid
Ridgegetstruth210 views 107 days ago -
Watch Later
 00:01
00:01IF EXPOSING WHAT THEY'RE DOING LEADS TO HATE, MAYBE THEY'RE THE PROBLEM
Sama_El924 views 1278 days ago